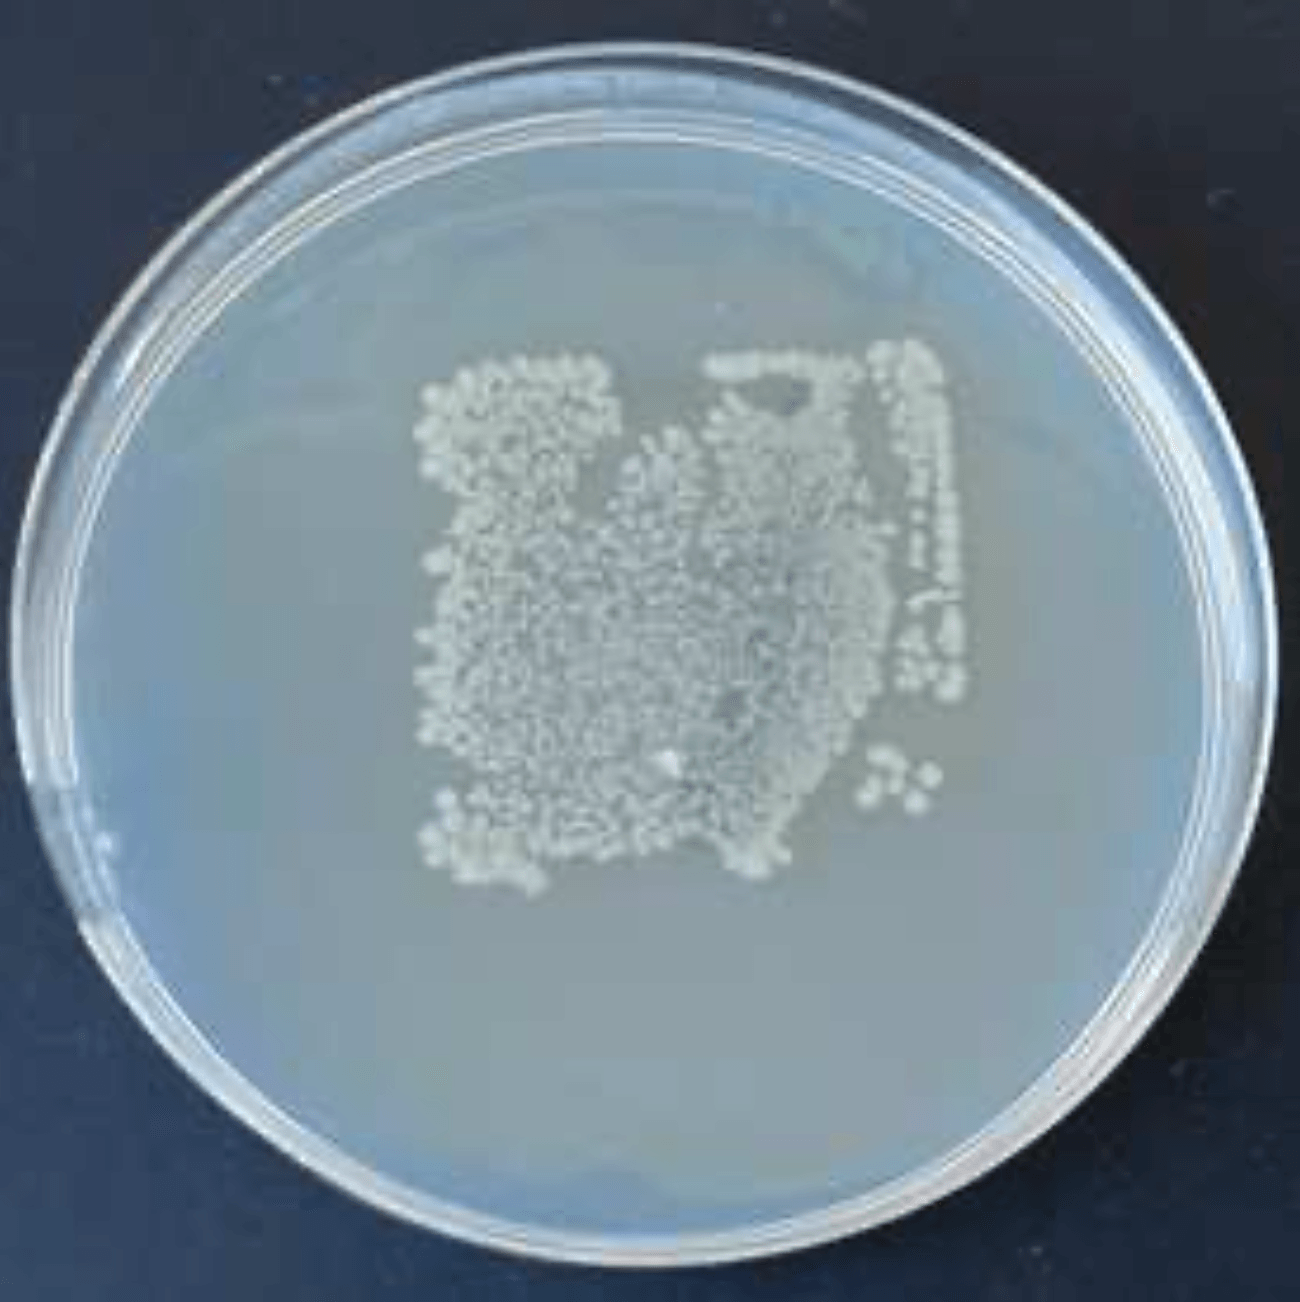
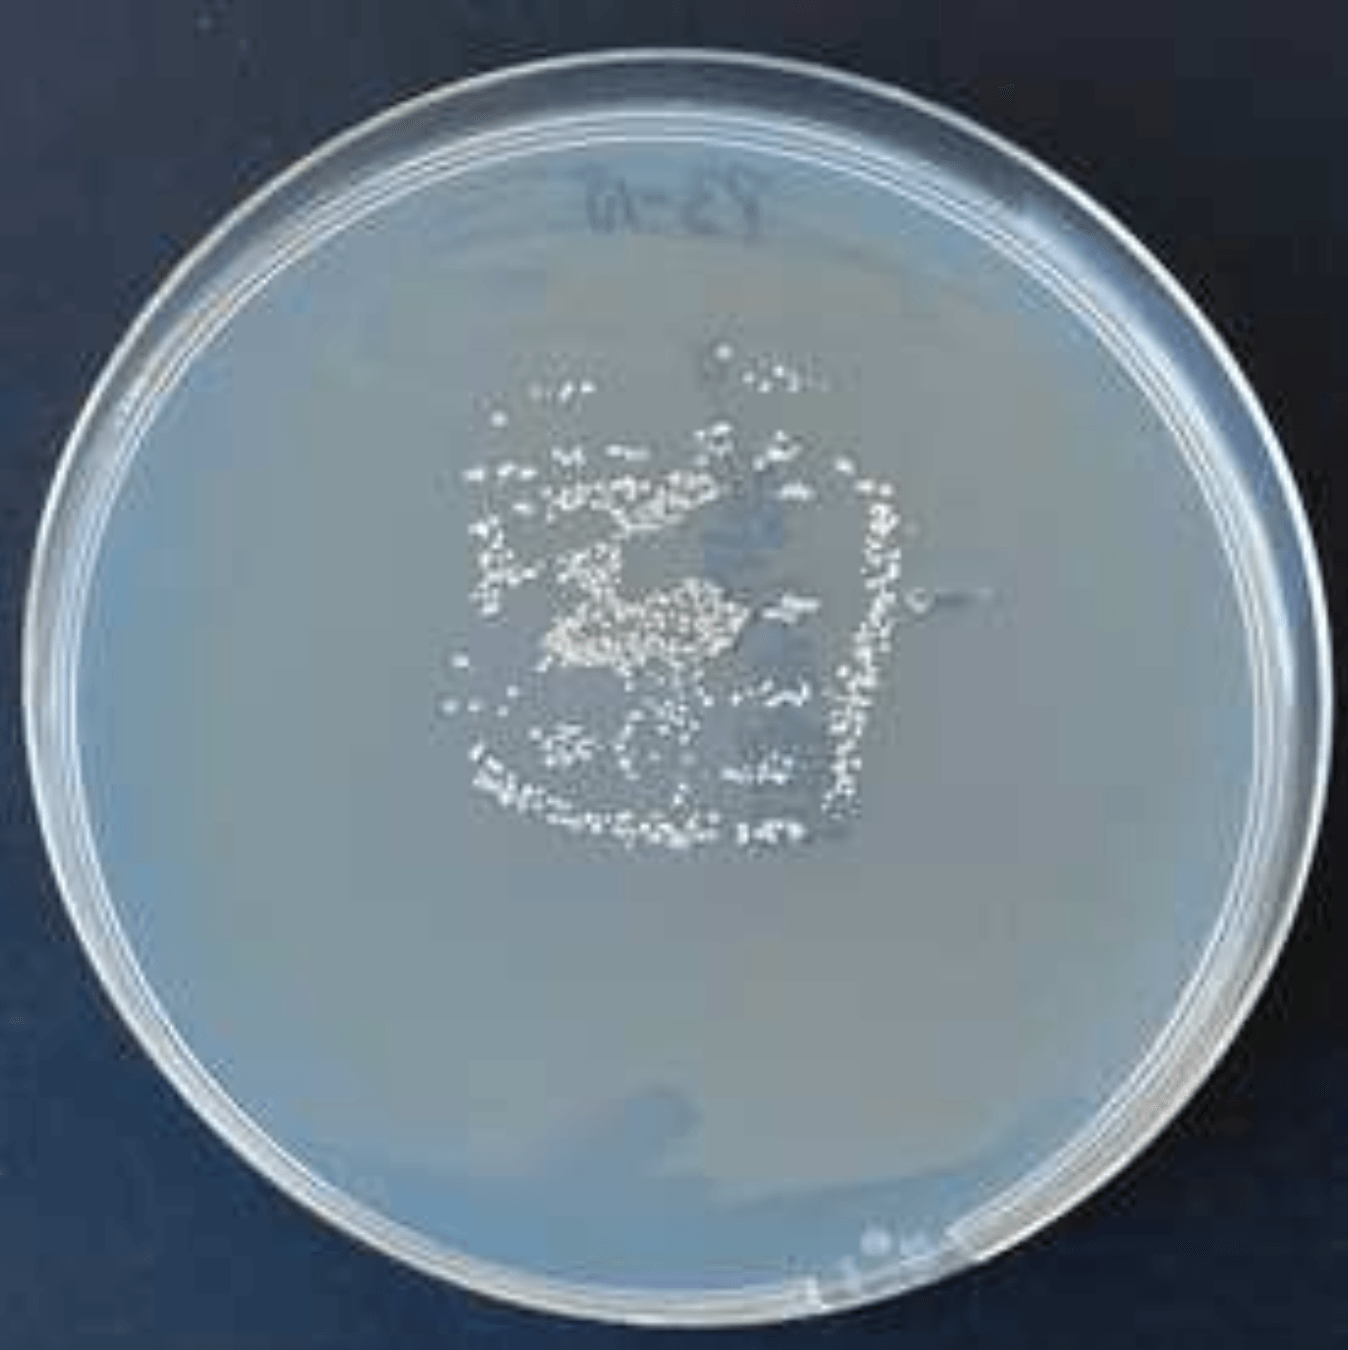

itHygieneProtect
the problem with bacteria and viruses
The fight against viruses and multi-resistant germs is of vital importance. Multi-resistant bacteria as well as coronaviruses and MRSA pose a particular risk in facilities for the elderly and sick. Mainly affected are the operative intensive care units, departments for burn injuries and newborn wards. But these germs are also found in old people's and nursing homes, outpatient services, public showers, churches and private households. These pathogens lie on all surfaces for days and weeks (coronaviruses are infectious on surfaces for up to 28 days!) and can be transmitted by touch.
Surfaces must therefore be disinfected regularly. However, this only helps until the next contamination, which can already occur through the next contact. This is where our
virucidal and bactericidal coating itHygieneProtect
comes into play.
our goal
We interrupt the chain of infection by making surfaces germ-free with our coatings and reducing the risk of infection by smear infection on surfaces!
The SOLUTION
itHygieneProtect
itHygieneProtect is an easy-to-apply, thin-layer and transparent coating for almost all smooth surfaces. itHygieneProtect permanently interrupts the chain of infection by killing 99% of bacteria and enveloped viruses such as influenza and corona within a very short time. This means that the surfaces are protected even after and between the cleaning and disinfection cycles.
why itHygieneProtect?
Permanent protection for surfaces against smear infections by bacteria and viruses for up to 3 years
Immediate effect - Reduces 99% of bacteria and viruses on surfaces within 30 minutes
Tested and confirmed by the independent test institutes EUROVIR® & MTC. Registered with the Federal Institute for Occupational Safety and Health
Developed by a research team from Gronau, Germany
Easy to apply, transparent, thin-layer, permanent and odorless coating
Saving of cleaning agents and cleaning staff - Surfaces can be cleaned with mild agents or water
Reduction of the environmental impact -
Saving of disinfectants, halogen-free, no free chlorine, bromine or fluorine
OUR PRODUCTS
itCoating H 610 N
✔︎ Biologically active - antibacterial and antiviral
✔︎ Permanent protection
✔︎ Easy to apply by wiping
✔︎ Yield: 1l for approx. 40-50m2
✔︎ 20-30 minutes drying time
itCoating K 620 V
✔︎ Biocide free Virus and bacteria
repellent protective layer
✔︎ Pore-tight surface
✔︎ Lasting protection - double the durability
✔︎ Easy to apply by wiping
✔︎ Yield: 1l for approx. 70-90m2
✔︎ 60-90 minutes drying time
✔︎ (Disinfecting) solvents
itCoating K 630 N
✔︎ Biologically active - antibacterial and antiviral
✔︎ Pore-tight surface
✔︎ Virus and bacteria repellent protective layer
✔︎ Lasting protection - double the durability
✔︎ Easy to apply by wiping
✔︎ Yield: 1l for approx. 70-90m2
✔︎ 60-90 minutes drying time
✔︎ (Disinfecting) solvents
THAT'S IT Lacquer Cloth
✔︎ Eliminates 99% of bacteria and viruses
✔︎ Permanent protection for up to 12 months
✔︎ Transparent, thin-layer, odorless, imperceptible coating
✔︎ Easy to apply by wiping
✔︎ For approx. 10 door handles or 10 meters of handrail
✔︎ 20-30 minutes drying time
GRIPS® Anti-Germ Foil
✔︎ Eliminates 99% of bacteria and viruses
✔︎ Permanent protection for up to 12 months
✔︎ Transparent, self-adhesivede 3D film
✔︎ Extremely pressure and scratch resistant
✔︎ Highly effective without the use of silver ions
✔︎ Easy to apply, even on uneven surfaces and handles
✔︎
Available in different sizes
Effectiveness confirmed!
itHygieneProtect
In addition to its bactericidal effect, it also has a systematic effect against the familie of the coronaviruses, which also include Influenza A Virus H1N1 and COVID-19 (SARS-CoV-2) and thus provides additional protection against smear infections from frequently touched surfaces such as door handles, counters, etc. Especially against enveloped viruses, to which belong to the class of coronaviruses, an accelerated decrease of the germs could be proven. Our products have the following inspections and tests carried out by the independent testing institutes EUROVIR® & Dr. Brünke MTC - Microbiological Testing Competence
has passed:
| Works against bacteria and viruses ... | ... which can cause the following diseases ... | ... are infectious on surfaces up to | >99% reduction within |
|---|---|---|---|
| Staphylococcus aureus | Pneumonia | 7 month | 15 minutes |
| Staphylococcus aureus MRSA | Pneumonia | 7 month | 15 minutes |
| Escherichia coli | Diarrheal diseases | 16 months | 15 minutes |
| Influenza A Virus H1N1 | Flu illnesses | 1-2 days | 30 minutes |
| Bovinen Coronavirus | Pneumonia | 9 days | 30 minutes |
exclusive pictures from the labor
Effect of itCoating H 610 N against bacteria Staphylococcus aureus:
In the first seconds

After 15 minutes

After 2 hours

Effect of itCoating H 610 N against bacteria Escherichia coli:
In the first seconds
After 15 minutes

After 2 hours

Effect of itCoating H 610 N against MRSA:
In the first seconds
After 15 minutes

After 2 hours

In addition, the skin compatibility of our coating was dermatologically determined very good from DERMATEST®
and passed the
safety requirements for toys (DIN EN 71-3)!
functionality
The coating has up to three excellent functional properties:
The pore-tight surface prevents enveloped viruses such as influenza and corona from diffusing into it.
The special surface tension ensures that the hydrophilic membranes of the virus envelope cannot adhere to the surface.
Biologically active compounds attack the virus envelope. This makes the virus envelope porous and the viruses die.
Areas of application
The coating can be used in almost all areas of life and on many surfaces made of wood, metal and many plastics. We are happy to help you if you have any questions about the possible applications.
APPLICATION
1. Saftey
Put on protective mask, gloves and goggles. Open the window and ventilate the room continuously while applying.
2. Cleaning
The more thorough the cleaning, the more convincing the result! Dirt, oils and fats must be completely removed with alcohol or an cleaner (recommendation: Frosch Spiritus Glas-Cleaner).
3. Masking
If necessary, cover surfaces that should not to be coated, such as locks.
4. Application
For large surfaces such as tables, doors, counters, etc. we recommend a paint tray and a standard window squeegee with a microfiber cover
1. Put the coating in the paint tray
2. Immerse window squeegee with microfiber cover and wipe off excess product on the squeegee
3. Pull the squeegee across the surface without applying pressure. Always pull and turn the squeegee in the same direction
For small surfaces such as door handles, window levers, cabinet handles, etc. we recommend a commercially available microfiber cloth
1. For doorknobs: Cover the keyhole and the door surface around the doorknob
2. Moisten the microfiber cloth with the coating
3. Wipe the surface with it (without applying pressure)
Ideal layer thickness for itCoating H 610 N: approx. 20 µm and for itCoating K 620 V and itCoating K 630 N: approx. 5 µm
5. Drying
itCoating H 610 N: Dry for 20-30 minutes. itCoating K 620 V und itCoating K 630 N: Dry for 60-90 minutes. Dispose of the microfiber cover / microfiber cloth in the residual waste. Clean the window squeegee, paint tray and squeegee immediately with alcohol.
THE Coating team
Our trained and certified partners offer you a unique hygiene concept and help you to guarantee your employees and customers optimal protection. We take care of the organization, application, quality control and documentation as a service for you.
training
Would you like to take over the application of our products yourself? Our workshops give you the necessary know-how in dealing with our products. After successful participation you will receive a certificate, materials and exclusive access to our B2B shop.
REFERENCES AND PARTNERS
Hygiene concept of the Rudolf Weber Group: Surface disinfection of the Weber Lodge, BayArena
Use biocidal products carefully. Always read the label and product information before use.
Technical data sheets and safety data sheets for the products can be downloaded from the contact form.






































































































